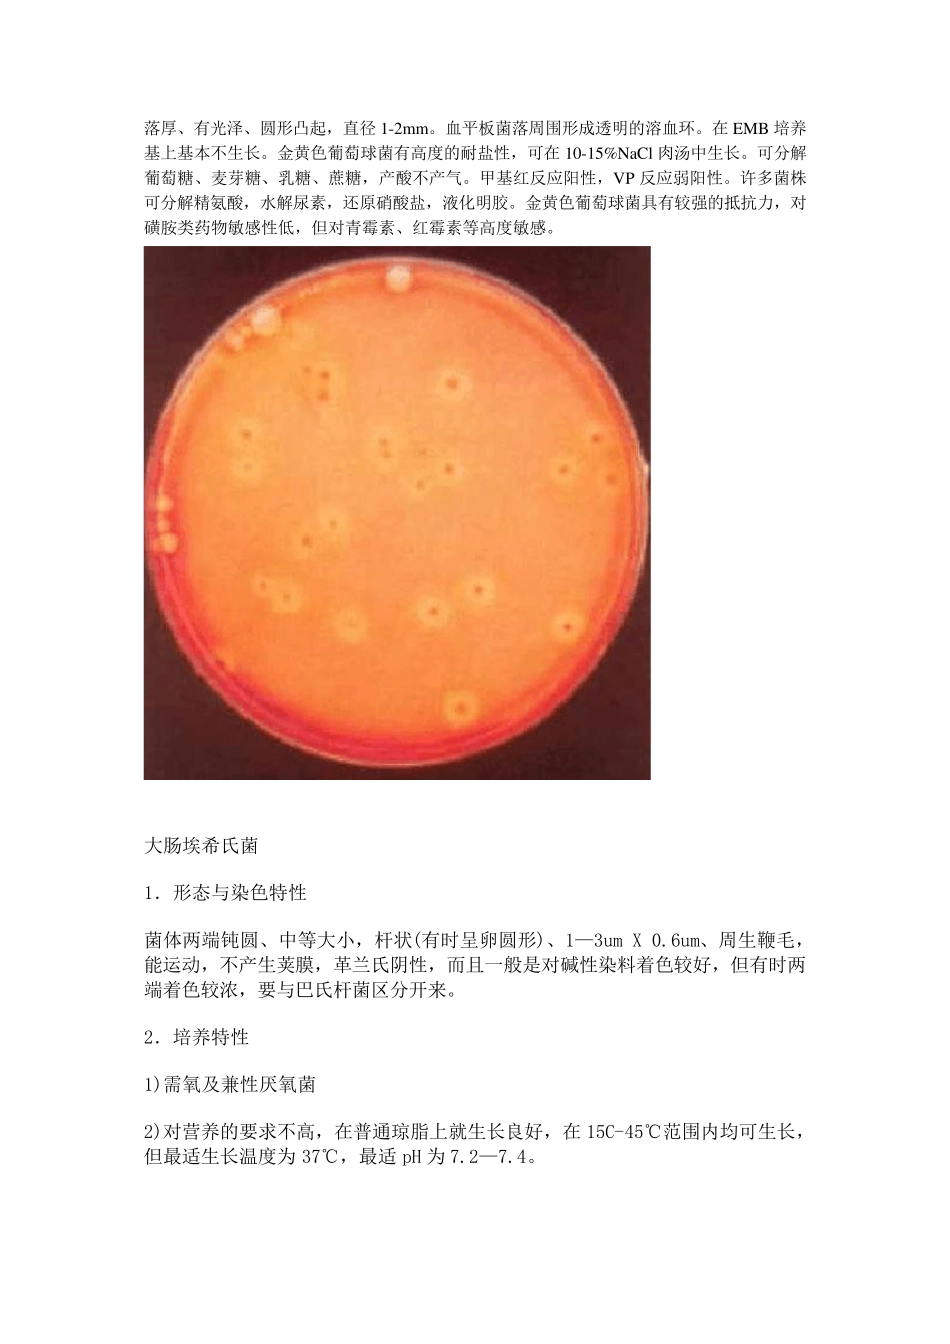
常见细菌及图片_第2页

肺炎克雷伯菌 1
形态结构:肺炎克雷伯菌肺炎亚种为革兰阴性杆菌,无鞭毛,无芽孢,标本直接涂片或在营养丰富培养基上的营养物可见菌体外有明显的荚膜
培养特性:兼性厌氧,营养要求不高,在初次分离培养基可形成较大、凸起灰白色黏液型的菌落
菌落大而厚实、光亮,相邻菌落容易发生融合,用接种蘸取时可挑出长丝状细丝
在麦康凯琼脂(MAC)培养基上形成较大的黏液型、红色的菌落,红色可扩散至菌落周围的培养基中
在伊红美蓝琼脂(EMB)上为大、粘稠、红色、易融合成一片的菌落
在血琼脂上为灰白色、大而黏、光亮且形成菌丝的菌落
生化特性:氧化酶阴性,葡萄糖产酸产气,动力阴性,吲哚阴性,脲酶阳性
金黄色葡萄球菌 典型的金黄色葡萄球菌为球型,直径0
8μm 左右,显微镜下排列成葡萄串状
金黄色葡萄球菌无芽胞、鞭毛,大多数无荚膜,革兰氏染色阳性
金黄色葡萄球菌营养要求不高,在普通培养基上生长良好,需氧或兼性厌氧,最适生长温度37°C,最适生长 pH 7
平板上菌落厚、有光泽、圆形凸起,直径1-2m m
血平板菌落周围形成透明的溶血环
在EMB 培养基上基本不生长
金黄色葡萄球菌有高度的耐盐性,可在10-15%NaCl 肉汤中生长
可分解葡萄糖、麦芽糖、乳糖、蔗糖,产酸不产气
甲基红反应阳性,VP 反应弱阳性
许多菌株可分解精氨酸,水解尿素,还原硝酸盐,液化明胶
金黄色葡萄球菌具有较强的抵抗力,对磺胺类药物敏感性低,但对青霉素、红霉素等高度敏感
大肠埃希氏菌 1.形态与染色特性 菌体两端钝圆、中等大小,杆状(有时呈卵圆形)、1—3um X 0
6um、周生鞭毛,能运动,不产生荚膜,革兰氏阴性,而且一般是对碱性染料着色较好,但有时两端着色较浓,要与巴氏杆菌区分开来
2.培养特性 1)需氧及兼性厌氧菌 2)对营养的要求不高,在普通琼脂上就生长良好,在15C-45℃范围内 均 可生长